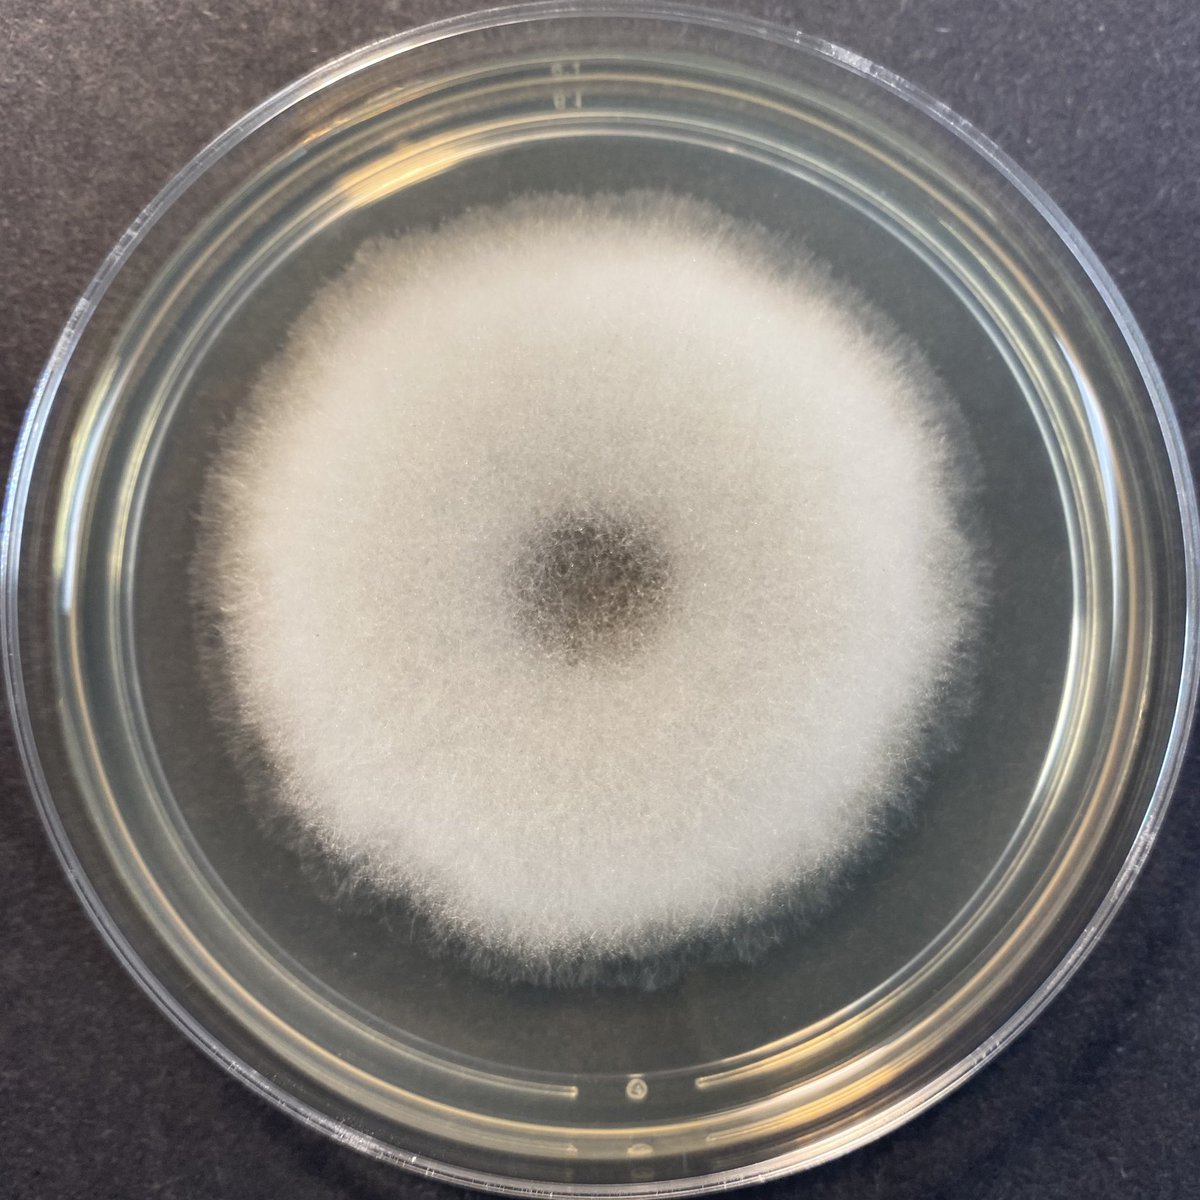
Ali Abdolrasouli tweet media

Sabitlenmiş Tweet

Our new study sheds light on coccidioidomycosis in South America! Investigating disease characteristics, genetic variation, and environmental factors, we identified 292 cases and 42 outbreaks in Brazil. Armadillo hunting linked to heightened risks. nature.com/articles/s4146…
English